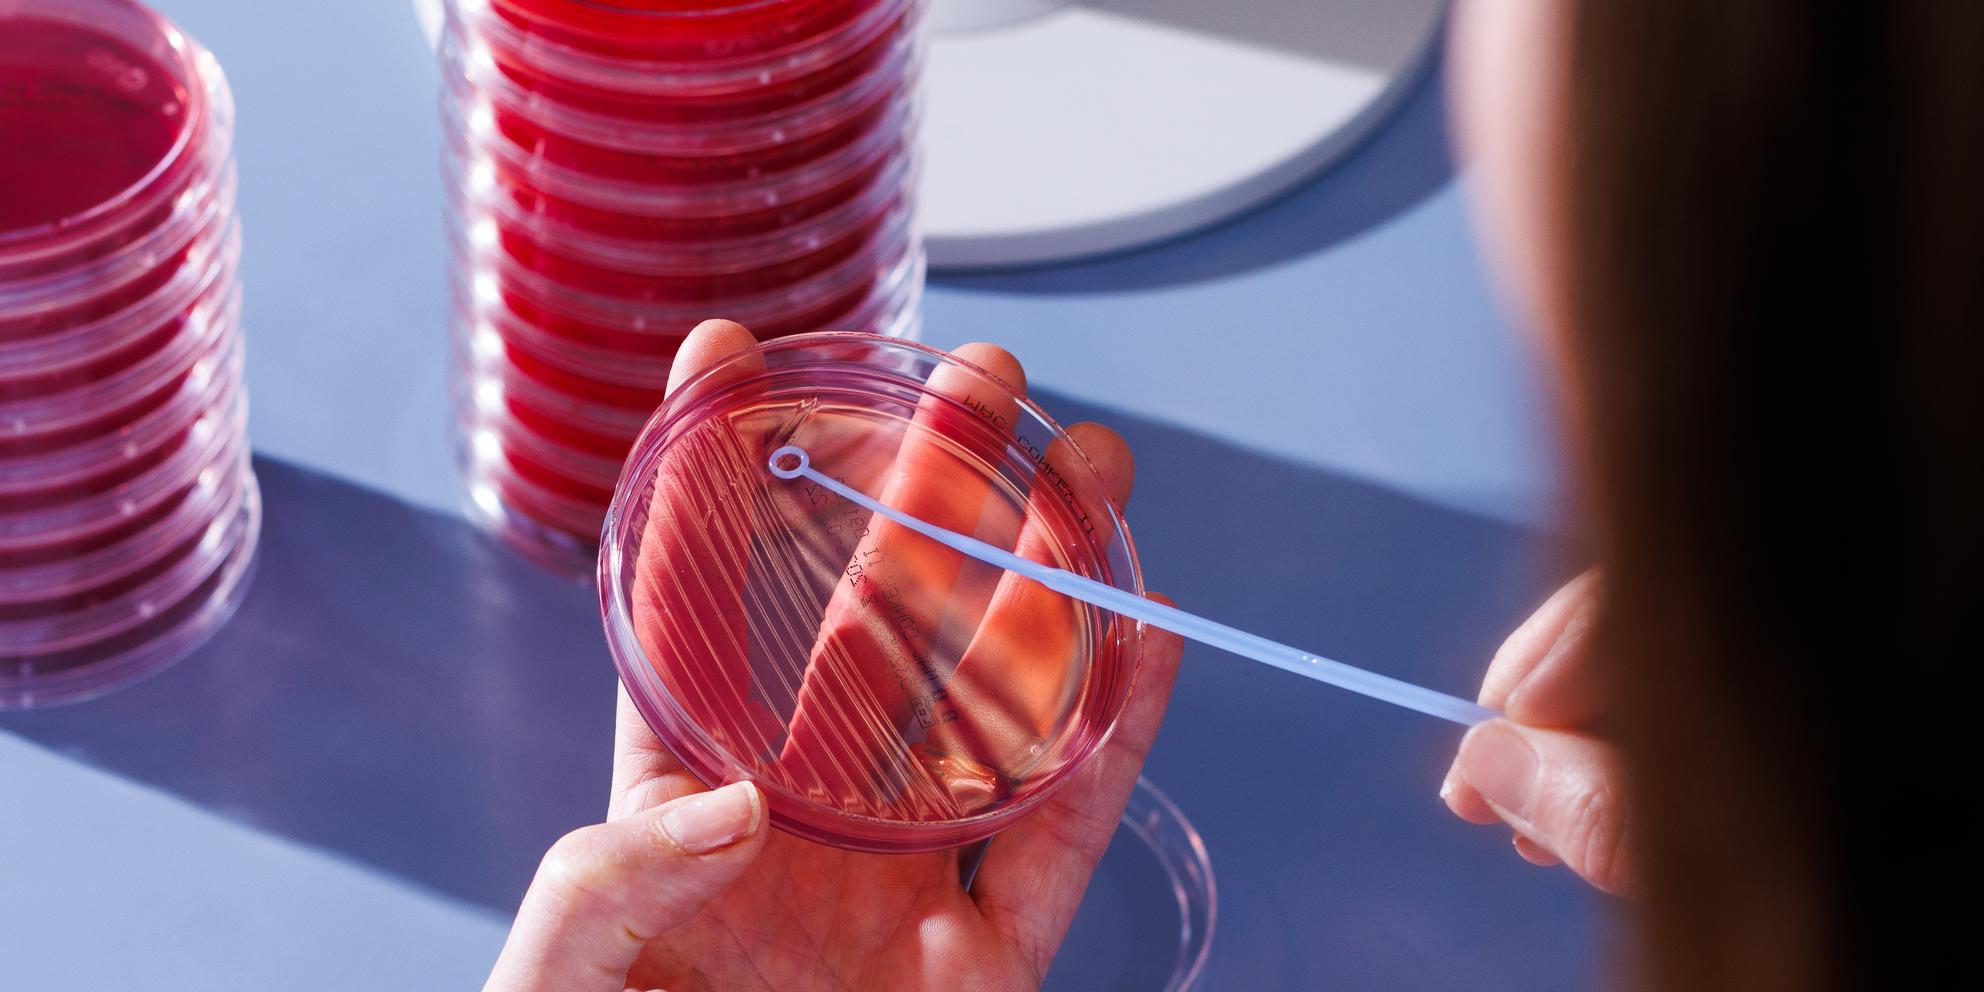
Bild von Mikrobiologie

Laboranalytik
Mikrobiologie
Infektionen brauchen schnelle Antworten: Ob HIV, Influenzae, Dysenterie- oder Sepsis-Erreger: Wir identifizieren Erreger rasch und präzise, bevor sie sich weiter ausbreiten. Unsere Abteilung für medizinische Mikrobiologie arbeitet mit modernsten, hochsensitiven Nachweismethoden, um Bakterien, Viren, Pilze und Parasiten zuverlässig zu detektieren.
Eine Kernaufgabe ist ebenfalls die Untersuchung der antibiotischen Empfindlichkeit von Krankheitserregern, damit ein Therapieerfolg ermöglicht wird.